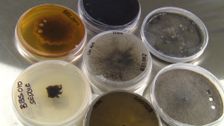
S30 E18: Landline

Landline
- Series
- News & Current Affairs
- NC
- CC
S34 E10: Western Queensland Flood Special
We look at Western Queensland's flood catastrophe and the long recovery ahead.
Airing
26 Apr, 17:14 - 17:43

26 Apr, 17:14 - 17:43

27 Apr, 1:31 - 2:00

27 Apr, 12:30 - 13:30

27 Apr, 12:30 - 13:30
Catch Up On ABC iview
- Info
S2025 E7: Landline
Expires Mon 31 Dec 2035 - Info
S2025 E2: Landline
Expires Mon 31 Dec 2035 - Info
S2025 E1: Landline
Expires Mon 31 Dec 2035 - Info
S2024 E42: Landline
Expires Mon 31 Dec 2035 - Info
S2024 E41: Landline
Expires Mon 31 Dec 2035 - Info
S2024 E37: Landline
Expires Mon 31 Dec 2035 - Info
S2024 E36: Landline
Expires Mon 31 Dec 2035 - Info
S2024 E33: Landline
Expires Mon 31 Dec 2035 - Info
S2024 E32: Landline
Expires Mon 31 Dec 2035 - Info
S2024 E30: Landline
Expires Mon 31 Dec 2035 - Info
S2024 E29: Landline
Expires Mon 31 Dec 2035 - Info
S2024 E27: Landline
Expires Mon 31 Dec 2035 - Info
S2024 E25: Landline
Expires Mon 31 Dec 2035 - Info
S2024 E23: Landline
Expires Mon 31 Dec 2035 - Info
S2024 E22: Landline
Expires Mon 31 Dec 2035 - Info
S2024 E19: Landline
Expires Mon 31 Dec 2035 - Info
S2024 E18: Landline
Expires Mon 31 Dec 2035 - Info
S2024 E16: Landline
Expires Mon 31 Dec 2035 - Info
S2024 E14: Landline
Expires Mon 31 Dec 2035 - Info
S2024 E12: Landline
Expires Mon 31 Dec 2035 - Info
S2024 E10: Landline
Expires Mon 31 Dec 2035 - Info
S2024 E9: Landline
Expires Mon 31 Dec 2035 - Info
S2024 E7: Landline
Expires Mon 31 Dec 2035 - Info
S2024 E5: Landline
Expires Mon 31 Dec 2035 - Info
S2024 E3: Landline
Expires Mon 31 Dec 2035 - Info
S2024 E2: Landline
Expires Mon 31 Dec 2035 - Info
S2023 E41: Landline
Expires Mon 31 Dec 2035 - Info
S2023 E36: Landline
Expires Mon 31 Dec 2035 - Info
S2023 E35: Landline
Expires Mon 31 Dec 2035 - Info
S2023 E33: Landline
Expires Mon 31 Dec 2035 - Info
S2023 E27: Landline
Expires Mon 31 Dec 2035 - Info
S2023 E26: Landline
Expires Mon 31 Dec 2035 - Info
S2023 E25: Landline
Expires Mon 31 Dec 2035 - Info
S2023 E23: Landline
Expires Mon 31 Dec 2035 - Info
S2023 E21: Landline
Expires Mon 31 Dec 2035 - Info
S2023 E20: Landline
Expires Mon 31 Dec 2035 - Info
S2023 E19: Landline
Expires Mon 31 Dec 2035 - Info
S2023 E17: Landline
Expires Mon 31 Dec 2035 - Info
S2023 E16: Landline
Expires Mon 31 Dec 2035 - Info
S2023 E15: Landline
Expires Mon 31 Dec 2035 - Info
S2023 E13: Landline
Expires Mon 31 Dec 2035 - Info
S2023 E12: Landline
Expires Mon 31 Dec 2035 - Info
S2023 E11: Landline
Expires Mon 31 Dec 2035 - Info
S2023 E9: Landline
Expires Mon 31 Dec 2035 - Info
S2023 E6: Landline
Expires Mon 31 Dec 2035 - Info
S2023 E5: Landline
Expires Mon 31 Dec 2035 - Info
S2023 E4: Landline
Expires Mon 31 Dec 2035 - Info
S2023 E3: Landline
Expires Mon 31 Dec 2035 - Info
S2023 E1: Landline
Expires Mon 31 Dec 2035 - Info
S2022 E42: Landline
Expires Mon 31 Dec 2035 - Info
S2022 E40: Landline
Expires Mon 31 Dec 2035 - Info
S2022 E39: Landline
Expires Mon 31 Dec 2035 - Info
S2022 E37: Landline
Expires Mon 31 Dec 2035 - Info
S2022 E36: Landline
Expires Mon 31 Dec 2035 - Info
S2022 E35: Landline
Expires Mon 31 Dec 2035 - Info
S2022 E33: Landline
Expires Mon 31 Dec 2035 - Info
S2022 E32: Landline
Expires Mon 31 Dec 2035 - Info
S2022 E31: Landline
Expires Mon 31 Dec 2035 - Info
S2022 E29: Landline
Expires Mon 31 Dec 2035 - Info
S2022 E27: Landline
Expires Mon 31 Dec 2035 - Info
S2022 E25: Landline
Expires Mon 31 Dec 2035 - Info
S2022 E24: Landline
Expires Thu 25 Nov 2027 - Info
S2022 E21: Landline
Expires Mon 31 Dec 2035 - Info
S2022 E20: Landline
Expires Mon 31 Dec 2035 - Info
S2022 E18: Landline
Expires Mon 31 Dec 2035 - Info
S2022 E16: Landline
Expires Mon 31 Dec 2035 - Info
S2022 E15: Landline
Expires Mon 31 Dec 2035 - Info
S2022 E13: Landline
Expires Mon 31 Dec 2035 - Info
S2022 E10: Landline
Expires Mon 31 Dec 2035 - Info
S2022 E8: Landline
Expires Mon 31 Dec 2035 - Info
S2022 E7: Landline
Expires Mon 31 Dec 2035 - Info
S2022 E5: Landline
Expires Mon 31 Dec 2035 - Info
S2022 E3: Landline
Expires Mon 31 Dec 2035 - Info
S2022 E2: Landline
Expires Mon 31 Dec 2035 - Info
S2022 E1: Landline
Expires Mon 31 Dec 2035 - Info
S2021 E43: Landline
Expires Tue 01 Jan 2036 - Info
S2021 E42: Landline
Expires Tue 01 Jan 2036 - Info
S2021 E41: Landline
Expires Tue 01 Jan 2036 - Info
S2021 E38: Landline
Expires Tue 01 Jan 2036 - Info
S2021 E37: Landline
Expires Tue 01 Jan 2036 - Info
S2021 E32: Landline
Expires Tue 01 Jan 2036 - Info
S2021 E31: Landline
Expires Tue 01 Jan 2036 - Info
S2021 E28: Landline
Expires Tue 01 Jan 2036 - Info
S2021 E25: Landline
Expires Tue 01 Jan 2036 - Info
S2021 E22: Landline
Expires Tue 01 Jan 2036 - Info
S2021 E21: Landline
Expires Tue 01 Jan 2036 - Info
S2021 E20: Bushfire Recovery Special
Expires Tue 01 Jan 2036 - Info
S2021 E17: Landline
Expires Tue 01 Jan 2036 - Info
S2021 E11: Anzac Special
Expires Tue 01 Jan 2036 - Info
S2021 E7: Landline
Expires Tue 01 Jan 2036 - Info
S2021 E6: Special - 30 Years
Expires Tue 01 Jan 2036 - Info
S2021 E5: Landline
Expires Tue 01 Jan 2036 - Info
S2021 E4: Landline
Expires Tue 01 Jan 2036 - Info
S2021 E1: Landline
Expires Tue 01 Jan 2036 - Info
S2020 E13: Anzac Tribute
Expires Sat 26 Apr 2025 - Info
S34 E10: Western Queensland Flood Special
Expires Mon 31 Dec 2035 - Info
S34 E9: Landline
Expires Mon 31 Dec 2035 - Info
S34 E8: Landline
Expires Mon 31 Dec 2035 - Info
S34 E6: Landline
Expires Mon 31 Dec 2035 - Info
S34 E5: Landline
Expires Mon 31 Dec 2035 - Info
S34 E3: Landline
Expires Mon 31 Dec 2035 - Info
S33 E40: Landline
Expires Mon 31 Dec 2035 - Info
S33 E39: Landline
Expires Mon 31 Dec 2035 - Info
S33 E38: Landline
Expires Mon 31 Dec 2035 - Info
S33 E35: Landline
Expires Mon 31 Dec 2035 - Info
S33 E34: Landline
Expires Mon 31 Dec 2035 - Info
S33 E31: Landline
Expires Mon 31 Dec 2035 - Info
S33 E28: Landline
Expires Mon 31 Dec 2035 - Info
S33 E26: Landline
Expires Mon 31 Dec 2035 - Info
S33 E21: Landline
Expires Mon 31 Dec 2035 - Info
S33 E20: Landline
Expires Mon 31 Dec 2035 - Info
S33 E17: Landline
Expires Mon 31 Dec 2035 - Info
S33 E15: Landline
Expires Mon 31 Dec 2035 - Info
S33 E13: Landline
Expires Mon 31 Dec 2035 - Info
S33 E11: Landline
Expires Mon 31 Dec 2035 - Info
S33 E8: Landline
Expires Mon 31 Dec 2035 - Info
S33 E6: Landline
Expires Mon 31 Dec 2035 - Info
S33 E4: Landline
Expires Mon 31 Dec 2035 - Info
S33 E1: Landline
Expires Mon 31 Dec 2035 - Info
S32 E42: Landline
Expires Mon 31 Dec 2035 - Info
S32 E40: Landline
Expires Mon 31 Dec 2035 - Info
S32 E39: Landline
Expires Mon 31 Dec 2035 - Info
S32 E38: Landline
Expires Mon 31 Dec 2035 - Info
S32 E37: Landline
Expires Mon 31 Dec 2035 - Info
S32 E34: Landline
Expires Mon 31 Dec 2035 - Info
S32 E32: Landline
Expires Mon 31 Dec 2035 - Info
S32 E31: Landline
Expires Mon 31 Dec 2035 - Info
S32 E30: Landline
Expires Mon 31 Dec 2035 - Info
S32 E29: Landline
Expires Mon 31 Dec 2035 - Info
S32 E28: Landline
Expires Mon 31 Dec 2035 - Info
S32 E24: Landline
Expires Mon 31 Dec 2035 - Info
S32 E22: Landline
Expires Mon 31 Dec 2035 - Info
S32 E18: Landline
Expires Mon 31 Dec 2035 - Info
S32 E14: Landline
Expires Mon 31 Dec 2035 - Info
S32 E10: Landline
Expires Mon 31 Dec 2035 - Info
S32 E8: Landline
Expires Mon 31 Dec 2035 - Info
S32 E7: Landline
Expires Mon 31 Dec 2035 - Info
S32 E2: Landline
Expires Mon 31 Dec 2035 - Info
S31 E41: Landline
Expires Mon 31 Dec 2035 - Info
S31 E38: Landline
Expires Mon 31 Dec 2035 - Info
S31 E34: Landline
Expires Mon 31 Dec 2035 - Info
S31 E30: Landline
Expires Mon 31 Dec 2035 - Info
S31 E28: Landline
Expires Mon 31 Dec 2035 - Info
S31 E26: Landline
Expires Mon 31 Dec 2035 - Info
S31 E23: Landline
Expires Mon 31 Dec 2035 - Info
S31 E22: Landline
Expires Mon 31 Dec 2035 - Info
S31 E19: Landline
Expires Mon 31 Dec 2035 - Info
S31 E17: Landline
Expires Mon 31 Dec 2035 - Info
S31 E14: Landline
Expires Mon 31 Dec 2035 - Info
S31 E12: Landline
Expires Mon 31 Dec 2035 - Info
S31 E11: Landline
Expires Mon 31 Dec 2035 - Info
S31 E9: Landline
Expires Mon 31 Dec 2035 - Info
S31 E6: Landline
Expires Mon 31 Dec 2035 - Info
S30 E40: Landline
Expires Tue 01 Jan 2036 - Info
S30 E39: Landline
Expires Tue 01 Jan 2036 - Info
S30 E36: Landline
Expires Tue 01 Jan 2036 - Info
S30 E35: Landline
Expires Tue 01 Jan 2036 - Info
S30 E34: Landline
Expires Tue 01 Jan 2036 - Info
S30 E33: Landline
Expires Tue 01 Jan 2036 - Info
S30 E30: Landline
Expires Tue 01 Jan 2036 - Info
S30 E29: Landline
Expires Tue 01 Jan 2036 - Info
S30 E27: Landline
Expires Tue 01 Jan 2036 - Info
S30 E26: Landline
Expires Tue 01 Jan 2036 - Info
S30 E24: Landline
Expires Tue 01 Jan 2036 - Info
S30 E23: Landline
Expires Tue 01 Jan 2036 - Info
S30 E19: Landline
Expires Tue 01 Jan 2036 - Info
S30 E18: Landline
Expires Tue 01 Jan 2036 - Info
S30 E16: Landline
Expires Tue 01 Jan 2036 - Info
S30 E15: Landline
Expires Tue 01 Jan 2036 - Info
S30 E14: Landline
Expires Tue 01 Jan 2036 - Info
S30 E13: Landline
Expires Tue 01 Jan 2036 - Info
S30 E12: Landline
Expires Tue 01 Jan 2036 - Info
S30 E10: Landline
Expires Tue 01 Jan 2036 - Info
S30 E9: Landline
Expires Tue 01 Jan 2036 - Info
S30 E8: Landline
Expires Tue 01 Jan 2036 - Info
S30 E3: Landline
Expires Tue 01 Jan 2036 - Info
S30 E2: Landline
Expires Tue 01 Jan 2036 - Info
S29 E42: Landline
Expires Sun 16 Nov 2025 - Info
S29 E41: Landline
Expires Sun 09 Nov 2025 - Info
S29 E40: Landline
Expires Sun 02 Nov 2025 - Info
S29 E39: Landline
Expires Sun 26 Oct 2025 - Info
S29 E38: Landline
Expires Sun 19 Oct 2025 - Info
S29 E37: Landline
Expires Sun 12 Oct 2025 - Info
S29 E36: Landline
Expires Sat 04 Oct 2025 - Info
S29 E35: Landline
Expires Sat 27 Sep 2025 - Info
S29 E34: Landline
Expires Sat 20 Sep 2025 - Info
S29 E33: Landline
Expires Sat 13 Sep 2025 - Info
S29 E32: Landline
Expires Sat 06 Sep 2025 - Info
S29 E31: Landline
Expires Sat 30 Aug 2025 - Info
S29 E30: Landline
Expires Sat 23 Aug 2025 - Info
S29 E28: Landline
Expires Sat 09 Aug 2025 - Info
S29 E27: Landline
Expires Sat 02 Aug 2025 - Info
S29 E26: Landline
Expires Sat 26 Jul 2025 - Info
S29 E25: Landline
Expires Sat 19 Jul 2025 - Info
S29 E24: Landline
Expires Sat 12 Jul 2025 - Info
S29 E23: Landline
Expires Sat 05 Jul 2025 - Info
S29 E22: Landline
Expires Sat 28 Jun 2025 - Info
S29 E21: Landline
Expires Sat 21 Jun 2025 - Info
S29 E20: Landline
Expires Sat 14 Jun 2025 - Info
S29 E19: Landline
Expires Sat 07 Jun 2025 - Info
S29 E18: Landline
Expires Sat 31 May 2025 - Info
S29 E17: Landline
Expires Sat 17 May 2025 - Info
S29 E17: Landline
Expires Sat 24 May 2025 - Info
S29 E15: Landline
Expires Sat 10 May 2025 - Info
S29 E14: Landline
Expires Sat 03 May 2025 - Info
Landline
Expires Sat 16 Aug 2025
More Like This
- Info
Villers-Bretonneux Dawn Service
4 airings - Info
ABC Late News
32 airings - Info
SBS World News Late Edition
14 airings - Info
NBC Today
18 airings - Info
Anzac Day Dawn Service
4 airings - Info
10's Late News
14 airings - Info
Planet America
16 airings - Info
NHK Japanese News
9 airings - Info
Anzac Day Dawn Service
2 airings - Info
Today
12 airings - Info
The Project
26 airings - Info
The Business
23 airings - Info
Telugu News DD Yadagiri
9 airings - Info
Sunrise
12 airings - Info
9News Morning
12 airings - Info
Entertainment Tonight
20 airings - Info
7.30
34 airings - Info
Indonesian News
16 airings - Info
Seven's National News At Noon
12 airings - Info
Gallipoli Dawn Service
2 airings